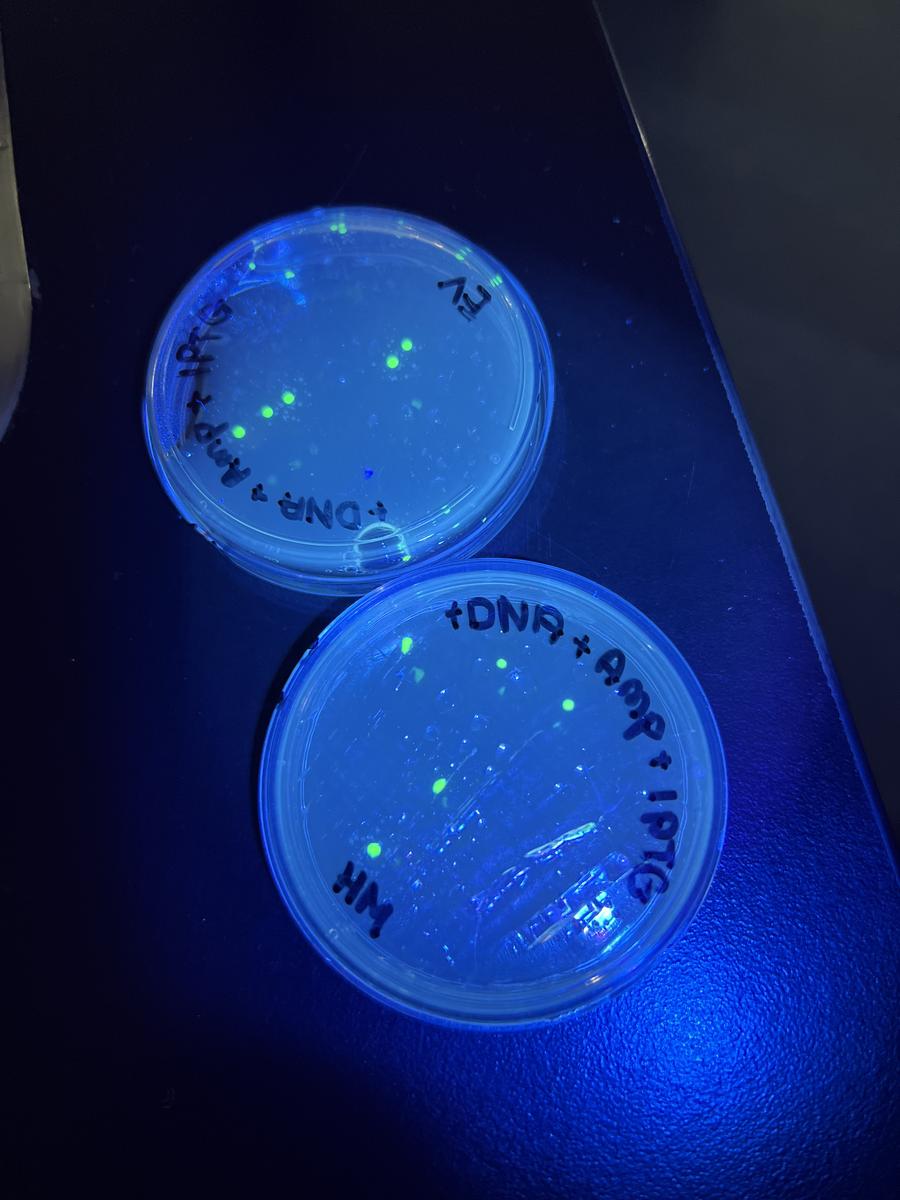
Gallery Image
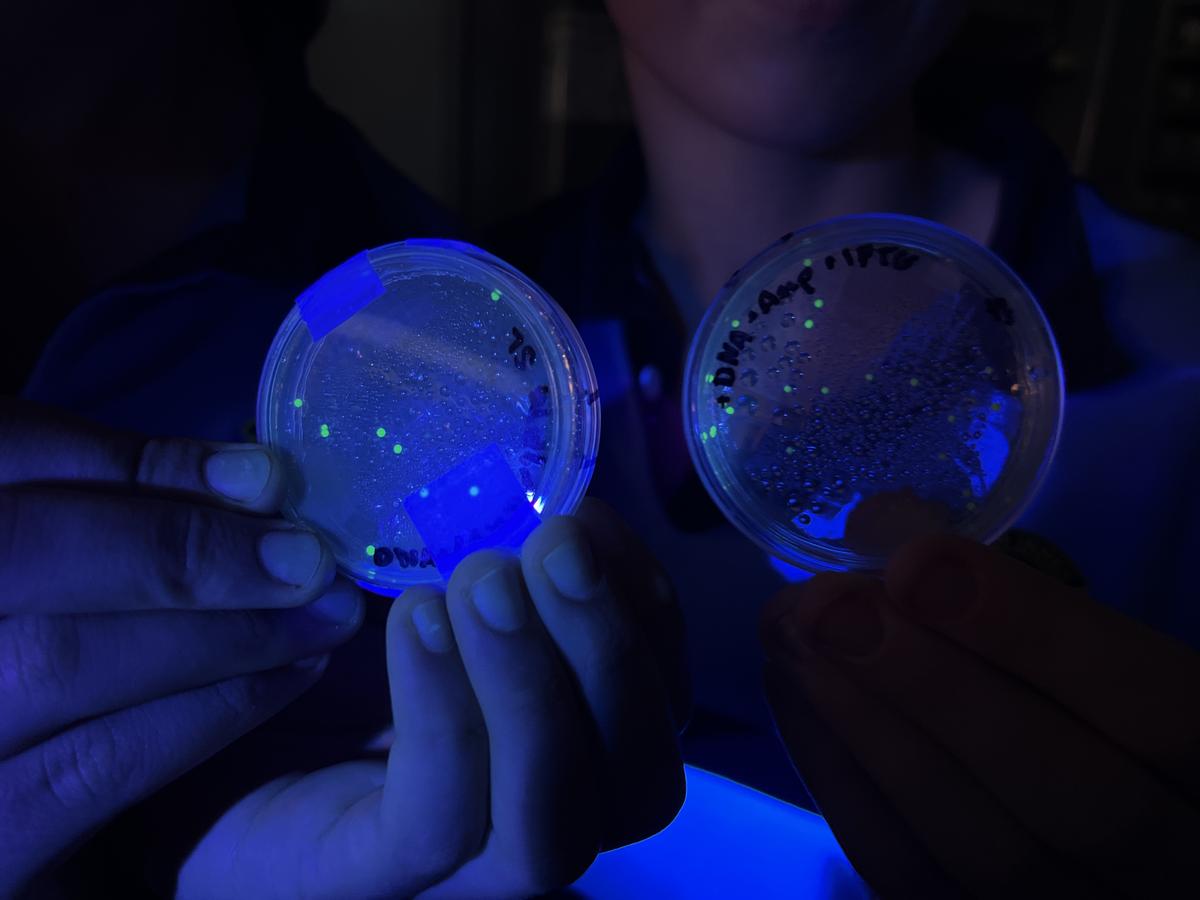
Gallery Image
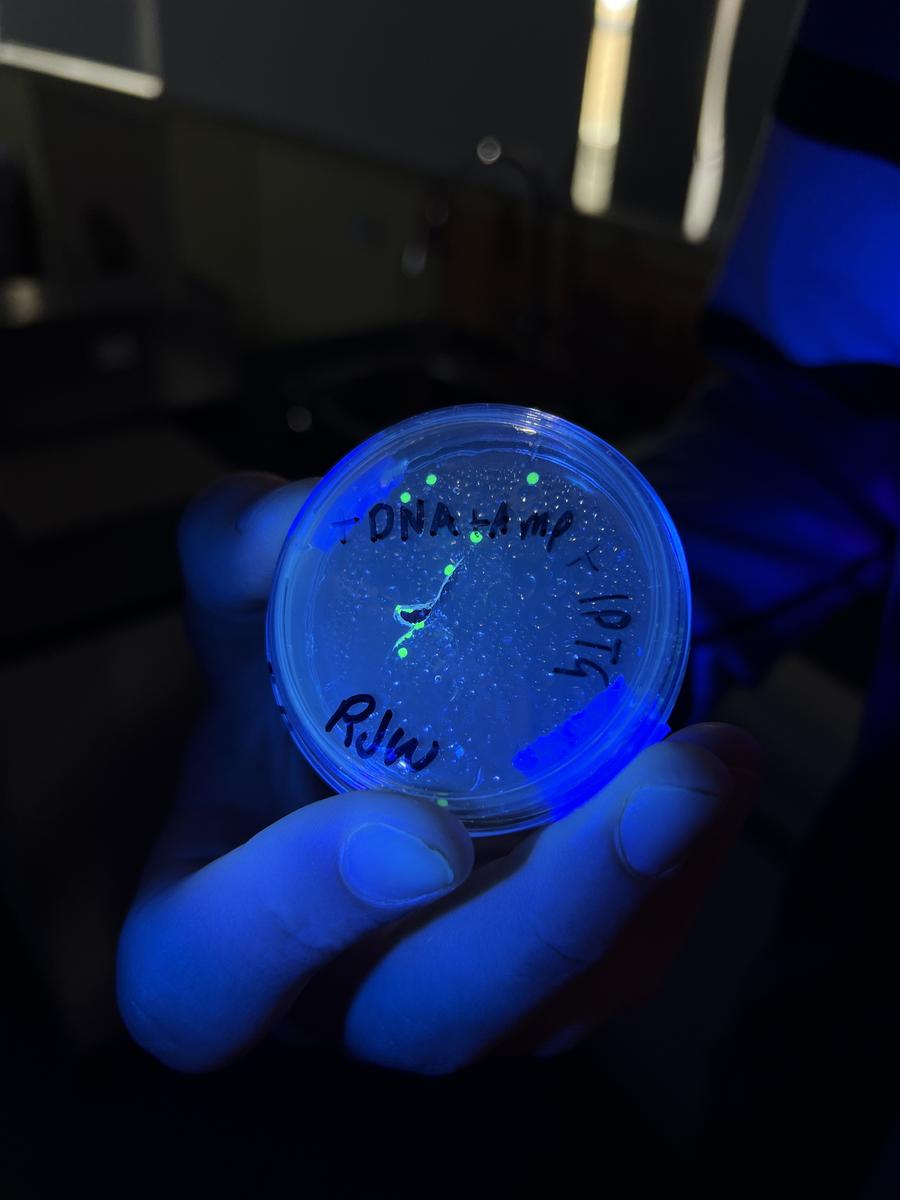
Gallery Image
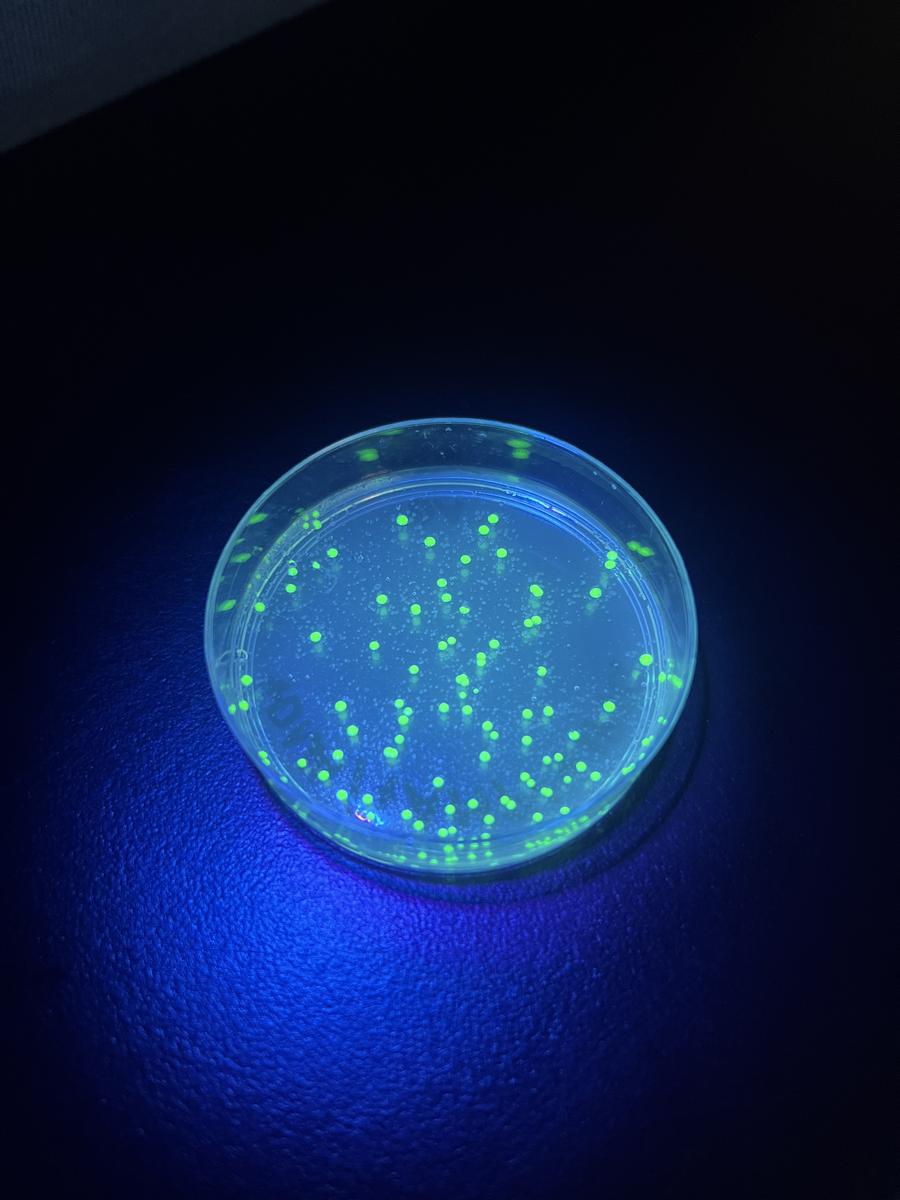
Gallery Image

BioBuzz

Yr.12 Biology has been busy learning about all things Biotechnology and Genetic Engineering.
In this activity titled "The E.coli Insulin Factory" the students were tasked with making a plasmid (circular piece of DNA) that contained the human gene for insulin and the gene for antibacterial resistance.
It may look simple but there is a lot of understanding required for this activity and this coming Wednesday they will get to make their own genetically modified E.coli that will glow in the dark!
Matt Dodds - Yr.12 Biology Teacher
Success!
Yr.12 Biology at Glen Innes High performed a Bacterial Transformation on E.coli and made it glow in the dark! Every group was successful in getting glowing colonies which is an awesome achievement.
We took a sample of E.coli and used a method called the "Heat Shock Method" whereby the E.coli was put on ice and then put in a water bath at 42°C which causes the E.coli to open pores in its membrane and take in a circular piece of DNA. This circular plasmid has the gene for Green Fluorescent Protein (GFP) on it and causes the E.coli to glow under UV light.
This activity took a lot of work on the students behalf to learn new microbiology skills and techniques. A special thank you to Clesa, our Lab Technician for helping make all the agar plates required for this amazing experiment.
Matt Dodds - Biology Teacher
Yr.12 have continued their study of Biotechnology with a practical on DNA Fingerprinting. Using brand new equipment for the first time the senior Biology class poured with own DNA electrophoresis gels, loaded the DNA samples using micropipettes and ran the gels.
The equipment worked perfectly and as you can see in the photos, the students got really well defined bands. We will follow this up with an analysis of these gels by examining the band patterns to determine the inheritance pattern of a disease. This unique experience has been in the works for a while and was possible due to the investment in quality equipment.
Mr.Dodds - Biology Teacher